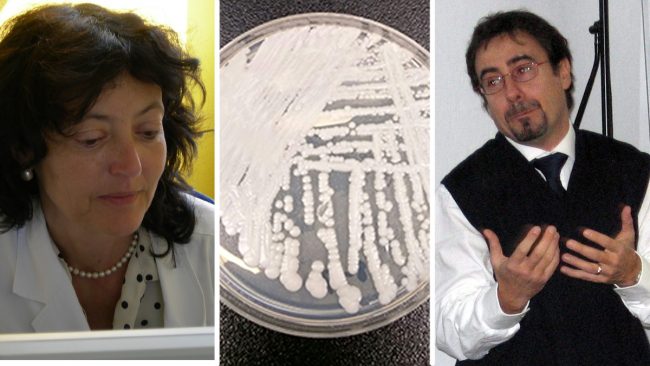

Nelle ultime 24 ore, fra le ricerche sul Web, a farsi largo a grandi spallate è stato un tema del tutto nuovo. E’ letteralmente in impennata nei trendig topics (argomenti di tendenza) il fungo “Candida auris”, un microrganismo divenuto istantaneamente famoso con la ferale nomea di “fungo killer che uccide in tre mesi”. Ma è davvero così? E c’è davvero d’aver paura? Lo abbiamo chiesto ad Antonella D’Arminio Monforte, direttore struttura Malattie infettive tropicali presso l’Asst Santi Paolo e Carlo di Milano, guidata dal direttore Matteo Stocco.
Candida auris: cos’è
Intanto, via il primo possibile equivoco: dimenticatevi boletus o ammanita, la Candida auris nulla a che fare con prati e boschi. E infatti si tratta di un micete lievitiforme, specie del più ampio genere Candida (responsabile di una delle infezioni più conosciute). Un ceppo tuttavia effettivamente molto aggressivo, ma il rischio d’imbattervisi è soprattutto limitato ai contesti ospedalieri.
“E’ una specie relativamente nuova, il cui studio è stato più intensamente avviato nel 2018 – spiega la professoressa D’Arminio – Sono noti solamente poco più di 600 casi al mondo e in Italia non se n’è ancora registrato uno. La Candida auris colpisce in particolare soggetti debolie immunodepressi (come trapiantati, dializzati o soggetti che hanno subito interventi), soprattutto in ambiente ospedaliero, dove il soggetto è più vulnerabile per via di cateteri, flebo e altre possibili porte d’ingresso per l’agente infettivo”.

Solo 600 ammalati in tutto il mondo
Quindi, solo 600 malati in tutto il mondo, impossibile conteggiare i contagiati, ma potrebbero essere qualche migliaio. Finora Italia esclusa, la maggior parte dei casi è stata registrata in Giappone (dov’è stato scoperto il patogeno) e Usa, più qualche evidenza anche in Europa e Asia. E può colpire soggetti deboli in un determinato ambiente. Niente panico, insomma.
“Esatto, malgrado il fungo sia effettivamente molto aggressivo(tanto che per gli immunodepressi la patologia esita nella morte nella stragrande maggioranza dei casi), tanto che, quando insorge anche solo il sospetto di un’infezione, il paziente va immediatamente isolato – spiega l’infettivologa – Negli Usa in un caso di decesso, è stata necessaria una bonifica intensiva degli ambienti, soffitti e pareti comprese”.
Una basilare norma di prevenzione
Il fungo provoca febbre, dolori muscolari e affaticamento, ma il problema soprattutto è che risulta resistente agli antibiotici. Come si può prevenire il rischio di contagio?
“Sembra banale, ma il primo presidio di sicurezza, soprattutto negli ambienti ospedalieri è in realtà molto semplice: domenica 5 maggio 2019 sarà la Giornata mondiale del lavaggio delle mani, la prima e più efficace buona pratica da adottare non solo in situazioni di particolare delicatezza, come nei nosocomi”.
Le iperboli sui siti d’informazione

“Il fungo che all’estero è già un’epidemia“, “Il fungo killer che terrorizza gli Usa“, “Super fungo mortale si sta diffondendo nel mondo senza fermarsi”, “Fungo che uccide sta facendo vittime in tutto il mondo“, “Nel 2050 potrebbe uccidere più dei tumori“. Questi alcuni dei titoli rimbalzati in Rete nelle ultime ore.
“Un approccio un po’ esagerato. Stiamo parlando di un fungo effettivamente particolare – spiega il medico piemontese Piergiorgio Bertucci, consulente malattie infettive presso gli ospedali di Chivasso e Ciriè – In primis perché non si è ancora capito esattamente quale sia il suo habitat: i funghi della famiglia della candida in genere vivono nel gastro-intestino, questa forma è stata scoperta inizialmente nell’orecchio (da qui il nome auris), ma ancora non è chiaro dove viva”.
Un germe difficile da individuare
Una diffusione davvero così emergenziale?
“In realtà, si diffonde così come tanti altri germi – continua lo specialista – ma a causa della sua particolare resistenza ad antibiotici e antimicotici, negli ospedali è necessario adottare tutte le attenzioni possibili: l’isolamento, immediatamente, quando viene individuato. Ma il problema è che parliamo di un patogeno comunque non facile da individuare“.
In attesa di un nuovo antibiotico
“Individuata per tempo, in soggetti non immunodepressi, la Candida auris può essere curata – conclude Bertucci – Il problema sono i soggetti deboli (che però corrono enormi rischi anche con altre forme molto meno aggressive di Candida), per i quali rappresenta un fattore di rischio altissimo: contiamo che l’industria farmaceutica riesca a sintetizzare in breve tempo antibiotici nuovi in grado di risultare efficaci. Faccio l’esempio della klebsiella pneumoniae, batterio che può provocare polmoniti batteriche, tristemente famoso allo stesso modo sul fronte delle infezioni ospedaliere: se vogliamo era molto più pericoloso rispetto alla Candida auris, fortunatamente sono stati sviluppati farmaci efficaci per contrastarlo”.
daniele.pirola@netweek.it